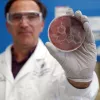
El CBD podría ser una solución contra las bacterias resistentes a antibióticos

Un equipo multidisciplinario de la Universidad de Medicina y Farmacia de Craiova, junto con la West University of Timișoara (Rumania), publicó en la revista Pharmaceutics los resultados de un estudio sobre un hidrogel en spray con propiedades antimicrobianas. La investigación, exploró la combinación de cannabidiol (CBD), plata coloidal e hialuronato de sodio dentro de un gel termoresponsivo.

Aspecto macroscópico del hidrogel HA-Ag-CBD en estado líquido ( a ) y gelificado ( b , c ).
El hidrogel fue diseñado para mantenerse líquido a temperatura ambiente y gelificarse al contacto con la piel, facilitando una aplicación uniforme y una liberación sostenida de los principios activos. La formulación conserva un pH fisiológico y presenta propiedades que la hacen apta para zonas corporales en movimiento, como codos o rodillas.
En ensayos in vitro, el hidrogel demostró actividad antimicrobiana frente a Staphylococcus aureus y Candida albicans y fue capaz de detener la proliferación de la Escherichia coli. Según los autores, el CBD tuvo una mayor capacidad antimicrobiana que la plata coloidal y su combinación produjo un efecto aditivo.
Los estudios de citotoxicidad en fibroblastos humanos indicaron una viabilidad celular superior al 70% en concentraciones terapéuticas, cumpliendo con la norma internacional ISO 10993-5. Este umbral es considerado seguro en aplicaciones biomédicas, lo que respalda la biocompatibilidad del hidrogel para potenciales usos tópicos.
Este tipo de formulaciones encajan en una línea de investigación donde confluyen varios elementos: el uso histórico de la plata en la curación de heridas, el creciente interés por las propiedades terapéuticas del CBD y la exploración de sistemas de liberación inteligente. Estudios anteriores ya habían sugerido sinergias entre cannabinoides y metales como la plata para prevenir infecciones cutáneas.
Aunque se trata de un ensayo preclínico, este trabajo aporta evidencia a una tendencia en el desarrollo de productos terapéuticos con cannabinoides que no apelan a su efecto psicoactivo, sino a su potencial biomédico. Frente a los discursos que reducen el cannabis a un problema legal o moral, la ciencia ofrece la posibilidad de que, bajo estándares rigurosos, el cannabis podría ampliar el arsenal terapéutico en el cuidado de la piel.